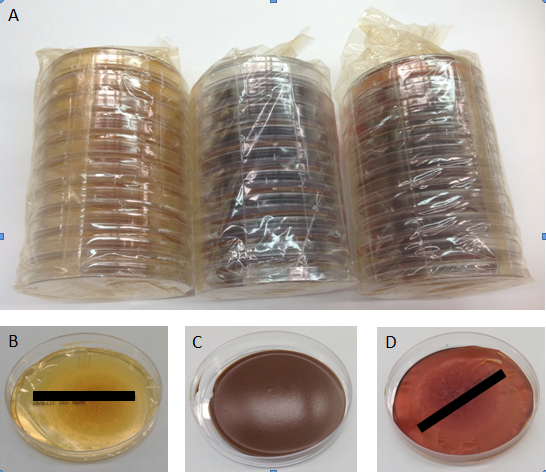
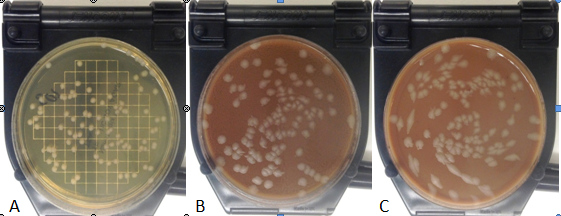

Journal of
eISSN: 2373-437X


Research Article Volume 2 Issue 7
Battelle's Biomedical Research Center, Columbus, USA
Correspondence: James V Rogers, PhD, Battelle, 505 King Avenue, JM-7Columbus, OH 43201, USA , Tel 614-424-5428
Received: October 23, 2015 | Published: December 29, 2015
Citation: Choi YW, Rogers JV (2015) Shelf-Life Assessment of Agar Plates Vacuum-Sealed in Nylon/Polyethylene Packaging Flushed with Nitrogen. J Microbiol Exp 2(7): 00075. DOI: 10.15406/jmen.2015.02.00075
In resource-limited nations, enhancing the shelf-life and stability of critical reagents and consumables is desired. This study evaluated the shelf-life of bacteriological plates in vacuum-sealed nylon/polyethylene packaging flushed with nitrogen (FlatPacks®). Tryptic soy agar (TSA) FlatPacks held at room temperature for 24 months did not change in appearance or texture and supported bacterial growth similar to Day 0 concentrations. In contrast, TSA plates from a different supplier (Vendor A) desiccated after 4 months of storage at room temperature. TSA, blood agar (BA), and chocolate agar (CA) FlatPacks subjected to desert-like storage and transport temperatures (60°C) for 30 days supported bacterial growth similar to FlatPacks held at room temperature or refrigerated; TSA, BA, and CA plates (Vendor A) desiccated within 7 days. The data suggest FlatPacks extend the shelf-life of TSA stored at room temperature when compared to traditional packaging. Additionally, TSA, BA, and CA FlatPacks support bacterial growth for at least 30 days when stored at 60°C. Based on the results of this study, the FlatPacks may help laboratories in resource-limited nations overcome infrastructure, refrigeration, and supply-chain deficiencies.
Keywords: shelf-life, vacuum-sealed packaging, tryptic soy agar, blood agar, chocolate agar
The importance of culture media for the growth, identification, and selection of microorganisms is underscored by its ubiquitous application across many fields of scientific research. These media can be typicallyclassified for the purposes of cultivation, maintenance, enrichment, differentiation, assays, and long-term storage. Each functional categorization is dependent upon the formulation and exhibits a finite shelf-life. For these culture media, the shelf-life refers to the length of time in which the medium retains the chemico-physical properties necessary to support the growth and characterization of the target microorganism.1
Typically, commercially-available solid growth media in Petri dishes (agar plates) possess a shelf-life that is short in duration, typically ranging from 30 to 90 days. Critical factors influencing the overall shelf-life and efficiency to support microbial growth include medium composition (i.e., general-purpose to unique formulations), sterilization method, storage temperature, exposure to light, and packaging.1 Various investigations have demonstrated the variability in the shelf-life of packaged agar plates formulated for the isolation, enrichment, selection, or drug sensitivity of bacteria, fungi, and parasites.1‒4 For example, Ulisse et al.,1 tested 12 separate media types differing in complexity, packed in shrink-wrap film, stored at 5°C, and originally coded for shelf-lives ranging from 3 to 30 days. Testing of weight reduction (water loss), sterility, pH, and ability to support bacterial growth revealed that these media could be assigned shelf-lives of 90 to 120 days. Ruijs et al.,2 investigated the shelf-life of prepared agar plates (with and without antibiotic/antimycotic) for the isolation and enrichment of Bordetella pertussis in which the plates were sealed in air-tight polyethylene bags and stored at 4°C at 65 to 70% relative humidity. When compared to freshly-prepared plates, culture assessments showed that the packaged selective media plates supported bacterial growth for up to 14 weeks. Additionally, Mueller-Hinton agar plates supplemented with 2% glucose and methylene blue and stored at 5°C performed within established guidelines for testing disk diffusion of antifungals for at least 30 days.3 Houźe et al.,4 showed that agar plates intended to measure the 50% inhibitory concentration of anti-malarial compounds against Plasmodium falciparum, the shelf-life of these plates ranged from 8 to 24weeks depending on the type of drug, storage temperature (4 or 25°C), and type of packaging (sealed, unsealed; with or without desiccant).
Many laboratories around the world utilize vendor-supplied media or have the capability to produce agar plates in-house in which the growth media are expended within the specified expiration date. However, there are developing countries in which electrical service is not wide-spread or reliable, and access to cold-storage facilities is limited. Therefore, being able to acquire culture plates that exhibit an extended shelf-life (i.e., >3 months) and maintain growth efficiency of microorganisms would be advantageous to overcome such deficiencies in infrastructure and unreliable product supply chains. The purpose of this study was two-fold. First, the ability of a general-purpose media (tryptic soy agar; TSA) to support bacterial growth after being stored in vacuum-sealednylon/polyethylene packaging flushed with nitrogen and maintained at room temperature for up to 24 months was evaluated. Second, packaged TSA, blood agar (BA), and chocolate agar (CA) were subjected to refrigeration, room temperature, andextreme temperature (e.g., desert conditions) for 30days and tested in parallel to determine their capacity to support the growth of bacteria.
Agar plates and packaging
FlatPack® agar plates used in this study were manufactured by NanoLogix, Inc. (Hubbard, OH) and included TSA, BA, and CA. Multiples of 10 for each type of agar plate were vacuum-sealed in 5-Mil nylon/polyethylene pouches flushed with nitrogen gas using a VP545 commercial gas flush chamber vacuum sealer (ARY, Inc., Kansas City, MO). For comparison, commercially-available TSA, BA, and CA were purchased from a separate vendor (referred to as Vendor A) in which stacks of 10 plates were sealed in the Vendor A-specific packages. All plates were stored at 2 to 8°C until the start of the study.
Test organism
To evaluate shelf-life, growth assessments were performed using Bacillus anthracis Ames spores (supplied by Battelle) prepared as previously described5 and suspended in sterile water at a concentration of approximately 1.0x109 colony forming units (CFU)/mL. Bacterial spores were used for this testing as they can be stored and remain viable at a known concentration for extended periods of time. All portions of testing were performed under biosafety level 3 (BSL-3) conditions in accordance with the Biosafety in Microbiological and Biomedical Laboratories (BMBL), 5th edition.
Duration of shelf-life study: 24 months
The long-term shelf-life evaluation was performed using TSA plates from NanoLogix and Vendor A conducted over a two-year period. A sufficient number of TSA plates were procured from both vendors as a single production lot in order to conduct the two year time-course assessment. To evaluate shelf-life, sets of FlatPacks and Vendor A TSA plates were stored in a laboratory at ambient conditions (20 to 22°C). Each month, the TSA from NanoLogix and Vendor A were removed from storage at ambient conditions and from refrigeration (the refrigerated TSA were allowed to equilibrate to ambient conditions prior to use). The plates were visually inspected for discoloration and other obvious signs of degradation. The B. anthracis Ames spore suspension was serially-diluted in cell culture-grade water (Sigma, St. Louis, MO, USA) and 100µL of each dilution were plated in triplicate and the plates were incubated for 18 to 24 hours at 37±2°C. To assess for contaminants, uninoculated plates were processed in parallel. Following incubation, plates were enumerated and CFU/mL determined by multiplying the average number of colonies per plate (countable range 25 to 250 CFU) by the reciprocal of the dilution.
Effect of temperature on shelf-life: 30 days
The effect of different temperatures (cold, room temperature, desert hot) on the ability of TSA, BA, and CA to support bacterial growth was evaluated for 30 days. The temperature to simulate storage and transit conditions within a hot desert environment (60°C) was chosen from the Department of Defense Test Method Standard for Environmental Engineering and Laboratory Tests (MIL-STD-810G; Climatic Category A2– Basic Hot). A sufficient number of TSA, BA, and CA plates from NanoLogix and Vendor A were stored inverted at 2 to 8°C, 20 to 22°C, or 60°C to test the shelf-life of samples at 1, 7, and 30 days. For the desert hot environmental condition, an Innova 4230 incubator (New Brunswick, Vernon Hills, IL, USA) set at 60°C was used. The Innova 4230 is a convection-style unit that uses air current to rapidly warm or cool the interior space; therefore, unlike a water-jacketed incubator, a convection-style unit can maintain a lower relative humidity. The temperature for each storage condition was monitored daily. At Days 1, 7 and 30, all three media types from NanoLogix and Vendor A were removed from each of the storage conditions and allowed to equilibrate to ambient conditions prior to use. The plates were visually inspected for discoloration and other obvious changes, such as desiccation or degradation. The B. anthracis Ames spore suspension was serially-diluted, plated, and incubated as described above. To assess for contaminants, uninoculated plates were processed in parallel. Following incubation, plates were enumerated and CFU/mL determined.
24-Month shelf-life study
The TSA FlatPacks stored at ambient conditions in a climate-controlled laboratory for 24 months supported the growth of B. anthracis Ames that ranged from 8.75 to 9.08 log10 CFU/mL (Figure 1). Colony size and morphology was consistent with B. anthracis Ames at each time period tested. For the TSA FlatPacks, the plates were not observed to change in appearance or texture, and remained moist and soft over the 24 months. However, TSA from Vendor A had completely desiccated by the fourth month under ambient conditions (Figure 2); therefore, the initial batch of a single production lot could no longer be used for testing. Thereafter, TSA from Vendor A was purchased for each subsequent time point and used within one week of receipt for the remainder of the investigation. For Vendor A, growth of B. anthracis Ames ranged from 8.87 to 9.11 log10 CFU/mL (Figure 1). No contaminating organisms were observed at any of the time points tested for both the FlatPacks and Vendor A TSA.

Figure 1 Mean log10 CFU/mL of Bacillus anthracis Ames determined on TSA from NanoLogix and Vendor when stored at room temperature for 24 months.At month 4, the Vendor A plates were desiccated and not useable.

Figure 2 Representative photos of (A) Vendor A and (B) NanoLogix TSA stored at room temperature for 4 months (left) as compared to plates store for less than 1 month (right).
Effect of temperature on 30-day shelf-life study
At Day 1, FlatPacks of TSA, BA, and CA stored at 2 to 8°C, 20 to 22°C, or 60°C exhibited no changes in color, texture, and overall condition with the exception of BA at 60°C in which the plates discolored from red to brown (Figure 3). Condensation was evident on the lids of all three media types for the FlatPacks stored at 60°C following removal from the incubator and allowed to equilibrate to room temperature. Similar observations were noted for all three types of agar plates from Vendor A. For all three media types and all storage conditions, growth of B. anthracis Ames for the FlatPacks ranged from 8.95 to 9.03 log10 CFU/mL, while growth on Vendor A plates was observed to range from 8.95 to 9.05 log10 CFU/mL (Table 1).

Figure 3 Representative photos of BA FlatPacks stored at 2 to 8°C, 20-22°C, or 60°C for 1 day. Note the darkening of BA held at 60°C (right).
|
Supplier/Storage condition |
TSA log10 CFU/mL |
BA log10 CFU/mL |
CA log10 CFU/mL |
|
Refrigerated (2 to 8°C) |
|||
|
FlatPacks |
9 |
8.95 |
8.95 |
|
Vendor A |
8.99 |
8.97 |
8.98 |
|
Ambient (20 to 22°C) |
|||
|
FlatPacks |
8.99 |
9 |
8.98 |
|
Vendor A |
9.01 |
8.98 |
8.97 |
|
Desert Hot (60°C) |
|||
|
FlatPacks |
8.96 |
9.03 |
8.99 |
|
Vendor A |
9.05 |
9.01 |
8.95 |
Table 1 Mean concentration of Bacillus anthracis Amesa on TSA, BA, and CA from FlatPacks and Vendor A plates stored at 2 to 8°C, 20 to 22°C, or 60°C for 1 day
aApproximately 9.00 log10 CFU/mL
By Day 7, FlatPacks of TSA, BA, and CA stored at 2 to 8°C, 20 to 22°C, or 60°C exhibited no changes in color, texture, and overall condition with the exception of BA discoloration at 60°C (similar to Day 1) and a slight darkening of the TSA (Figure 4). Similar condensation was observed as Day 1. For Vendor A plates stored at 2 to 8°C and 20 to 22°C, no visible changes were noted; however, plates held at 60°C exhibited discoloring to the packaging and the TSA, BA, and CA agar plates were desiccated (Figure 5). For all three media types and all storage conditions, growth of B. anthracis Ames for the FlatPacks ranged from 8.94 to 9.03 log10 CFU/mL (Table 2). For the Vendor A plates stored at 2 to 8°C and 20 to 22°C, growth of B. anthracis Ames ranged from 8.94 to 8.98 log10 CFU/mL (Table 2). Due to the desiccation of the Vendor A agar plates held at 60°C, spread plating could not be performed.

Figure 4 Representative photos of TSA FlatPacks stored at 2 to 8°C, 20-22°C, or 60°C for 7 days. Note the darkening of TSA held at 60°C (right).
Figure 5 Representative photos of media from Vendor A in packaged form (A) and single plates (B,C,D) stored at 60°C for 7 days. Note the desiccation of the TSA (B), CA (C), and BA (D).
|
Supplier/Storage condition |
TSA log10 CFU/mL |
BA log10 CFU/mL |
CA log10 CFU/mL |
|
Refrigerated (2 to 8°C) |
|||
|
FlatPacks |
8.98 |
9 |
8.95 |
|
Vendor A |
8.94 |
8.96 |
8.97 |
|
Ambient (20 to 22°C) |
|||
|
FlatPacks |
8.94 |
8.97 |
8.97 |
|
Vendor A |
8.95 |
8.95 |
8.98 |
|
Desert Hot (60°C) |
|||
|
FlatPacks |
9.03 |
8.96 |
8.95 |
|
Vendor A |
-b |
- |
- |
Table 2 Mean concentration of Bacillus anthracis Amesa on TSA, BA, and CA from FlatPacks and Vendor A plates stored at 2 to 8°C, 20 to 22°C, or 60 °C for 7 days
aApproximately 9.00 log10 CFU/mL
b “-“ indicates that data could not be obtained for these plates due to desiccation
When FlatPacks of TSA, BA, and CA were stored for 30 days at 2 to 8°C, 20 to 22°C, or 60°C the only additional observed changes to the agar plates to that observed at Day 7 was the appearance of slight wrinkles on the surface of some of the TSA and CA plates; however, these wrinkles did not affect the ability to perform spread plating. Similar to Day 7 observations, Vendor A plates stored at 2 to 8°C and 20 to 22°C appeared normal, whereas plates stored at 60°C exhibited packaging discoloration and complete desiccation of all TSA, BA, and CA agar plates. For the TSA, BA, and CA FlatPacks held under all storage conditions, growth of B. anthracis Ames ranged from 8.91 to 9.06 log10 CFU/mL (Table 3). It should be noted that B. anthracis Ames colonies on TSA from FlatPacks stored at 60°C for 30 days were smaller, but still countable, when compared to the BA and CA (Figure 6). The growth of B. anthracis Ames ranged from 8.93 to 9.01 log10 CFU/mL for the Vendor A plates stored at 2 to 8°C and 20 to 22°C (Table 3). No data could be collected from the Vendor A TSA, BA, or CA plates stored at 60°C due to desiccation.
|
Supplier/Storage condition |
TSA log10 CFU/mL |
BA log10 CFU/mL |
CA log10 CFU/mL |
|
Refrigerated (2 to 8°C) |
|||
|
FlatPacks |
8.93 |
8.91 |
8.96 |
|
Vendor A |
9.01 |
9 |
8.99 |
|
Ambient (20 to 22°C) |
|||
|
FlatPacks |
8.97 |
8.91 |
9.06 |
|
Vendor A |
8.93 |
8.95 |
8.93 |
|
Desert Hot (60°C) |
|||
|
FlatPacks |
8.97 |
8.99 |
9.03 |
|
Vendor A |
-b |
- |
- |
Table 3 Mean concentration of Bacillus anthracis Amesa on TSA, BA, and CA from FlatPacks and Vendor A plates stored at 2 to 8°C, 20 to 22°C, or 60°C for 30 days
aApproximately 9.00 log10 CFU/mL
b “-“ indicates that data could not be obtained for these plates due to desiccation
Figure 6 Representative growth and morphology of Bacillus anthracis Ames on TSA (A), CA (B), and BA (C) from FlatPacks stored at 60°C for 30 days.
At Days 1, 7, and 30, no contamination was observed on any of the media types for both the FlatPacks and Vendor A plates stored at 2 to 8°C and 20 to 22°C. Contamination was not observed on the different FlatPack media stored at 60°C for all three time periods evaluated. At 60°C, Vendor A plates exhibited no contaminants at Day 1; desiccation prevented assessment at Days 7 and 30.
In many resource-limited nations throughout the world, clinical sample analysis and public health surveillance revolves around the central reference laboratory (CRL) principle in which this main laboratory is typically located in the capital with several intermediate and/or peripheral facilities throughout the rest of the nation.6 The CRL typically commands most of the resources, whereas the more remote laboratories are often under-equipped, lack the adequate infrastructure, possess little to no standardization, and are subject to deficiencies in the supply chain of consumables.7‒9 Consequences resulting from these deficiencies could lead to the degradation or expiration of critical laboratory consumables such as agar media used for the isolation, identification, and antimicrobial susceptibility testing needed for clinical diagnosis. Under circumstances in which media cannot be prepared fresh at each time of use or are supplemented with compounds susceptible to degradation, enhancing the shelf-life and stability of critical reagents and consumables for peripheral laboratories in resource-limited nations would be advantageous logistically and monetarily. For both general use and specialized media, studies have demonstrated that various forms of packaging(i.e., thermo-sealed, air-tight polyethylene bags) in combination with refrigerated storage conditions can lengthen shelf-life when compared to unsealed plates.1,2,4 Approaches such as these provide a pathway to address some of the issues common to the laboratories peripheral to CRLs. However, these methods rely on the availability of consistent refrigeration, which is often lacking in resource-limited nations.
For decades, the food industry has studied the effects of modified atmosphere packing (MAP) to extend the shelf-life of fresh or processed foods.10‒12 The MAP process typically reduces the level of oxygen in the packaged items by replacing with nitrogen, carbon dioxide, argon, or a combination of these gases with the intent of maintaining appearance, texture, flavor, and nutritive value. Following the basic MAP principle, the FlatPacks tested in this study are vacuum-sealed in nylon/polyethylene pouches and flushed with nitrogen in order to extend shelf-life of both general-purpose and enrichment media. In addition to increasing the length of time for prepared media to be stored at 2 to 8°C, the utility of FlatPacks to preserve the integrity of the culture media and support bacterial growth under ambient and desert hot storage and transit conditions was investigated.
TSA FlatPacks stored at room temperature for 24 months supported the growth of B. anthracis in which the mean concentration (9.03 log10 CFU/mL) at 24 months was within 1.2% of the mean concentration (8.92 log10 CFU/mL) at Day 0. In contrast, TSA plates from Vendor A were desiccated and not useable at the 4-month time point; therefore, new plates had to be purchased from Vendor A for each subsequent time point, which prevented a true room temperature shelf-life determination over the 24-month investigation. These data indicate that the shelf-life (in months) for the FlatPack TSA was at least 6-fold greater than the Vendor A TSA when stored at room temperature.
When subjected to temperature simulating storage and transit conditions within a hot desert environment for 30 days, TSA, BA, and CA FlatPacks supported growth of B. anthracis, while exhibiting some discoloration and surface wrinkles. All packaged TSA, BA, and CA plates from Vendor A had desiccated by Day 7 when stored at 60°C; it is unclear as to the exact day in which these plates had deteriorated and deemed not useable for dilution plating. Therefore, using 7 days as the shelf-life threshold for packaged Vendor A, plates subjected to extreme temperatures may not be conducive for use in many resource-limited nations throughout the world possessing an unreliable supply-chain for laboratory materials and reagents. Such a short shelf-life would be most problematic for laboratories peripheral to the CRLs. In contrast, the results of this study indicate that the TSA, BA, and CA FlatPacks stored at 60°C supported B. anthracis growth similar to the respective FlatPacks stored refrigerated and at room temperature. This suggests that the FlatPacks may provide a greater time window of usability (i.e., 30 days) than plates packaged similar to Vendor A when transported or stored in hot climates.
When preparing media for shelf-life determinations, recommended procedures include the use of standardized suspensions of reference test strains (e.g., Staphylococcus aureus) no more than 5 passages beyond the seed stock, use the suspension within 2 hours (or 24 hours if stored at 2 to 8°C), there should be not more than 100 CFU per plate, and the average CFU for the new media batch should be within a factor of 2 from a previously accepted media batch. Moreover, it is suggested that the plates be wrapped in cellophane or plastic and placed at 2 to 8°C in the dark for packaging and storage.13 It should be noted that this study evaluated the growth B. anthracis spores from a single suspension rather than preparing fresh test organism cultures each day of testing. The use of spores enabled the temporal evaluation a single preparation with a known concentration without the potential for day-to-day variability associated with freshly-prepared test organisms. Moreover, the observed difference in the minimum and maximum log10 CFU/mL throughout the 24 month shelf-life assessment using this spore suspension was approximately 3.8%.
Based on results of this study, the FlatPack packaging extends the shelf-life of TSA stored at room temperature when compared to a common form of packaging (i.e., Vendor A). Moreover, the FlatPacks containing TSA and the enriched media BA and CA support bacterial growth for at least 30 days when stored under extreme “hot” temperatures. As this study evaluated bacterial growth, colony size and morphology, sterility, and changes in color and texture, there are additional parameters such as changes in pH, agar volume (mass), agar consistency, and biochemical responses along with the use of a panel of standard reference organisms that could be tested in support of further shelf-life assessments.1,13
This work was funded by NanoLogix, Inc. and Battelle’s Biomedical Research Center.
Authors declare that there is no conflict of interest.

©2015 Choi, et al. This is an open access article distributed under the terms of the, which permits unrestricted use, distribution, and build upon your work non-commercially.